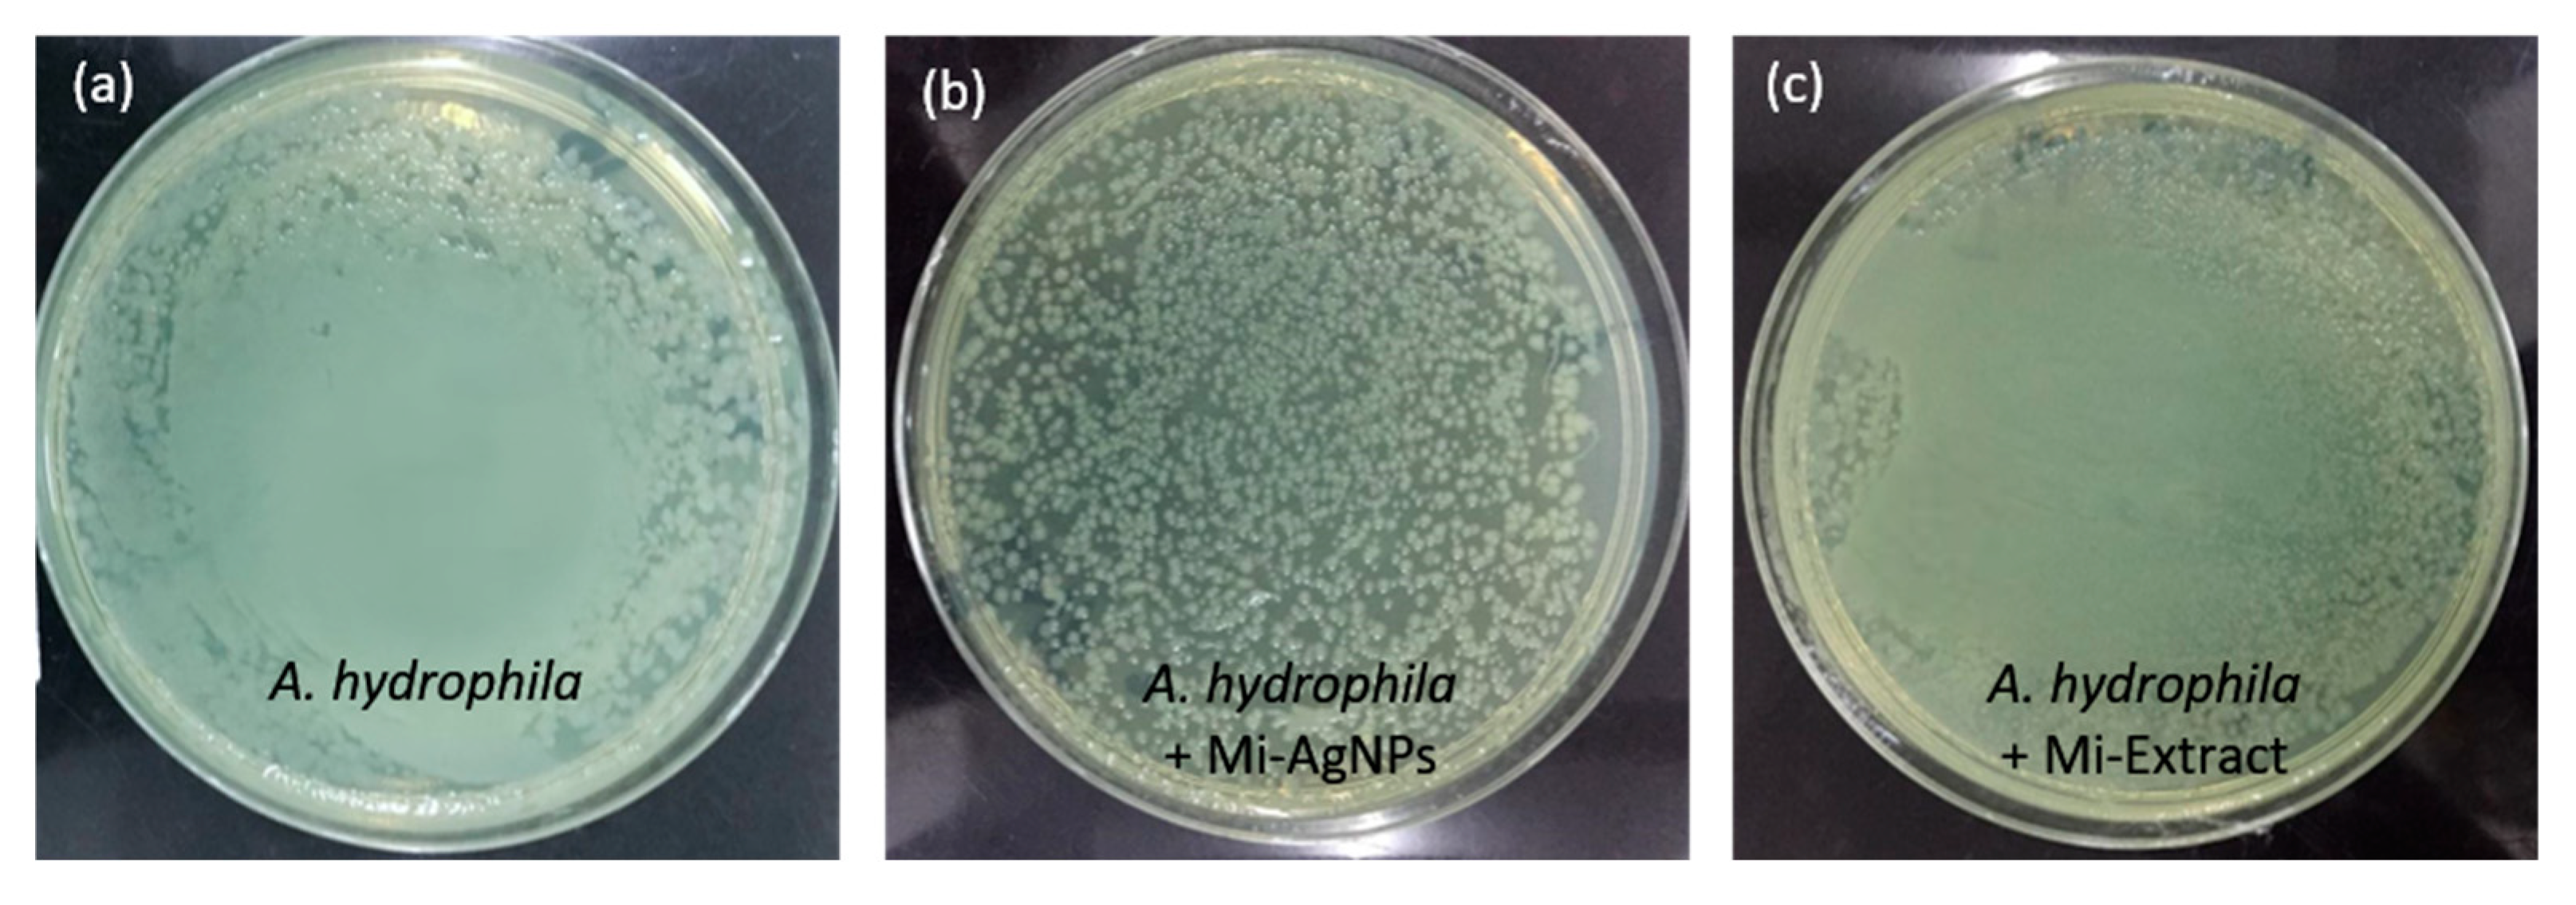

In-Vivo Bactericidal Potential of Mangifera indica Mediated Silver Nanoparticles against Aeromonas hydrophila in Cirrhinus mrigala
Abstract
1. Introduction
2. Materials and Methods
2.1. Extraction of Mangifera indica Leaves and Green Synthesis of AgNPs
2.2. Characterization of Biosynthesized Mi-AgNPs
2.3. Experimental Organism and Conditions
2.4. In-Vivo Challenge Assays
- G1: control (unchallenged),
- G2: A. hydrophila challenged,
- G3: A. hydrophila challenged + Mi-AgNPs-administered in aquaria water on a daily basis at a concentration of 0.01 mg/L),
- G4: A. hydrophila challenged + Mi-AgNPs-administered in aquaria water on a daily basis at a concentration of 0.05 mg/L),
- G5: A. hydrophila challenged + Mi-AgNPs-administered in aquaria water on a daily basis at a concentration of (0.1 mg/L),
- G6: A. hydrophila challenged + M. indica extract-administered in aquaria water at a concentration of 0.1mg/L),
- G7: Mi-AgNPs treated- Mi-AgNPs-administered in aquaria water on a daily basis at a concentration of (0.1mg/L).
2.5. Biochemical Parameters
2.6. Blood Parameters
2.7. Histopathological Evaluation
2.8. Oxidative Stress Analysis
2.9. CFU Assay
2.10. Statistical Analysis
3. Results and Discussion
3.1. Optical Analysis by UV-Vis Spectroscopy
3.2. Structural Analysis of Mi-AgNPs by XRD
3.3. FTIR Analysis of Mi-Extract and Mi-AgNPs
3.4. Morphological and Compositional Analysis of Mi-AgNPs
3.5. The Potential Mechanism for Biosynthesis of Mi-AgNPs
3.6. Biochemical Analysis
3.7. Blood Analysis
3.8. Histopathological Analysis
3.9. Oxidative Stress Biomarkers
3.10. CFU Analysis
4. Conclusions
Author Contributions
Funding
Institutional Review Board Statement
Data Availability Statement
Acknowledgments
Conflicts of Interest
References
- FAO. The State of World Fisheries and Aquaculture 2020. In Sustainability in Action; FAO: Rome, Italy, 2020. [Google Scholar] [CrossRef]
- Pradeepkiran, J.A. Aquaculture role in global food security with nutritional value: A review. Transl. Anim. Sci. 2019, 3, 903–910. [Google Scholar] [CrossRef] [PubMed]
- Guillen, J.; Natale, F.; Carvalho, N.; Casey, J.; Hofherr, J.; Drun, J.-N.; Fiore, G.; Ginin, M.; Zanzi, A.; Martinsohn, J. Global seafood consumption footprint. Ambio 2019, 48, 111–122. [Google Scholar] [CrossRef] [PubMed]
- Tavares-Dias, M.; Martins, M.L. An overall estimation of losses caused by diseases in the Brazilian fish farms. J. Parasit. Dis. 2017, 41, 913–918. [Google Scholar] [CrossRef]
- Kanwal, K.; Raza, M.A.; Manzoor, F.; Arshad, M.; Farzana Rashid, F.; Riaz, S.; Pervaiz, S.; Naseem, S. In vivo anti-proliferative activity of silver nanoparticles against Pseudomonas aeruginosa in freshwater Labeo rohita. Appl. Nanosci. 2019, 9, 2039–2049. [Google Scholar] [CrossRef]
- Walczak, N.; Puk, K.; Guz, L. Bacterial Flora Associated with Diseased Freshwater Ornamental Fish. J. Vet. Res. 2017, 61, 445–449. [Google Scholar] [CrossRef]
- Swann, L.; White, M.R. Diagnosis and treatment of “Aeromonas hydrophila” infection of fish. In Aquaculture Extension; Illinois-Indiana Sea Grant Program: West Lafayette, IN, USA, 1991. [Google Scholar]
- Zhou, H.; Gai, C.; Ye, G.; An, J.; Liu, K.; Xu, L.; Cao, H. Aeromonas hydrophila, an Emerging Causative Agent of Freshwater-Farmed Whiteleg shrimp Litopenaeus vannamei. Microorganisms 2019, 7, 450. [Google Scholar] [CrossRef]
- Hayatgheib, N.; Moreau, E.; Calvez, S.; Lepelletier, D.; Pouliquen, H. A review of functional feeds and the control of Aeromonas infections in freshwater fish. Aquac. Int. 2020, 28, 1083–1123. [Google Scholar] [CrossRef]
- Nugroho, R.A.; Sari, Y.P.; Hardi, E.H. Inclusion of Myrmecodia pendens bulb Extract in the Diet Stimulates Immune Response in Clarias gariepinus against Aeromonas hydrophila. Jordan J. Biol. Sci. 2020, 13, 463–468. [Google Scholar]
- Stratev, S.; Odeyemi, Q.A. Antimicrobial resistance of Aeromonas hydrophila isolated from different food sources: A mini-review. J. Infect. Public Health 2016, 9, 535–544. [Google Scholar] [CrossRef]
- Pal, S.; Ray, S.D.; Homechaudhuri, S. Evaluation of in vivo non-specific immunity and oxidative stress in Labeo rohita (Hamilton, 1822) infected with Aeromonas hydrophila as biomarker for early diagnosis. Int. J. Fish. Aquat. 2015, 3, 116–124. [Google Scholar]
- Makarov, V.V.; Love, A.J.; Sinitsyna, O.V.; Makarova, S.S.; Yaminsky, I.V.; Taliansky, M.E.; Kalinina, N.O. “Green” nanotechnologies: Synthesis of metal nanoparticles using plants. Acta Naturae 2014, 6, 35–44. [Google Scholar] [CrossRef]
- Kurcheti, P.P.; Dhayanath, D.; Mary, A.J.; Jeena, J.; Alim, H. Biosynthesis of Nanoparticles—A New Horizon in Fish Biomedicine. J. Aquac. Fish. 2020, 4, 035. [Google Scholar] [CrossRef]
- Sarkar, B.; Mahanty, A.; Gupta, S.K.; Choudhury, A.R.; Daware, A.; Bhattacharjee, S. Nanotechnology: A next-generation tool for sustainable aquaculture. Aquaculture 2022, 546, 737330. [Google Scholar] [CrossRef]
- Dar, A.H.; Rashid, N.; Majid, I.; Hussain, S.M.; Ahmed Dar, M.A. Nanotechnology interventions in aquaculture and seafood preservation. Crit. Rev. Food Sci. Nutr. 2020, 60, 1912–1921. [Google Scholar] [CrossRef]
- Lashin, I.; Fouda, A.; Gobouri, A.A.; Azab, E.; Mohammedsaleh, Z.M.; Makharita, R.R. Antimicrobial and In Vitro Cytotoxic Efficacy of Biogenic Silver Nanoparticles (Ag-NPs) Fabricated by Callus Extract of Solanum incanum L. Biomolecules 2021, 11, 341. [Google Scholar] [CrossRef] [PubMed]
- Fouda, A.; Awad, M.A.; AL-Faifi, Z.E.; Gad, M.E.; Al-Khalaf, A.A.; Yahya, R.; Hamza, M.F. Aspergillus flavus-Mediated Green Synthesis of Silver Nanoparticles and Evaluation of Their Antibacterial, Anti-Candida, Acaricides, and Photocatalytic Activities. Catalysts 2022, 12, 462. [Google Scholar] [CrossRef]
- Sim, W.; Barnard, R.T.; Blaskovich, M.A.T.; Ziora, Z.M. Antimicrobial Silver in Medicinal and Consumer Applications: A Patent Review of the Past Decade (2007–2017). Antibiotics 2018, 7, 93. [Google Scholar] [CrossRef] [PubMed]
- Politano, A.D.; Campbell, K.T.; Rosenberger, L.H.; Sawyer, R.G. Use of silver in the prevention and treatment of infections: Silver review. Surg. Infect. 2013, 14, 8–20. [Google Scholar] [CrossRef] [PubMed]
- Raza, M.A.; Kanwal, Z.; Rauf, A.; Sabri, A.N.; Riaz, S.; Naseem, S. Size- and Shape-Dependent Antibacterial Studies of Silver Nanoparticles Synthesized by Wet Chemical Routes. Nanomaterials 2016, 6, 74. [Google Scholar] [CrossRef]
- Bruna, T.; Maldonado-Bravo, F.; Jara, P.; Caro, N. Silver Nanoparticles and Their Antibacterial Applications. Int. J. Mol. Sci. 2021, 22, 7202. [Google Scholar] [CrossRef]
- Camacho-Jiménez, L.; Álvarez-Sánchez, A.R.; Mejía-Ruíz, C.H. Silver nanoparticles (AgNPs) as antimicrobials in marine shrimp farming: A review. Aquac. Rep. 2020, 18, 100512. [Google Scholar] [CrossRef]
- Shah, K.A.; Patel, M.B.; Patel, R.J.; Parmar, P.K. Mangifera Indica (Mango). Pharmacogn. Rev. 2010, 4, 42–48. [Google Scholar] [CrossRef] [PubMed]
- Philip, D. Mangifera indica leaf-assisted biosynthesis of well-dispersed silver nanoparticles. Spectrochim. Acta A Mol. Biomol. Spectrosc. 2011, 78, 327–331. [Google Scholar] [CrossRef]
- Ogholbeyg, A.B.; Kianvash, A.; Hajalilou, A.; Abouzari-Lotf, E.; Zarebkohan, A. Cytotoxicity characteristics of green assisted-synthesized superparamagnetic maghemite (γ-Fe2O3) nanoparticles. J. Mater. Sci. Mater. 2018, 29, 12135–12143. [Google Scholar] [CrossRef]
- Nasrollahzadeh, M.; Sajadi, S.M.; Maham, M. Green synthesis of palladium nanoparticles using Hippophae rhamnoides Linn leaf extract and their catalytic activity for the Suzuki–Miyaura coupling in water. J. Mol. Catal. A-Chem. 2015, 396, 297–303. [Google Scholar] [CrossRef]
- Rajeshkumar, S.; Bharath, L.V. Mechanism of plant-mediated synthesis of silver nanoparticles -A review on biomolecules involved, characterization and antibacterial activity. Chem. Biol. Interact. 2017, 273, 219–227. [Google Scholar] [CrossRef]
- Shawkey, A.M.; Rabeh, M.A.; Abdulall, A.K.; Abdellatif, A.O. Green nanotechnology: Anticancer Activity of Silver Nanoparticles using Citrullus colocynthis aqueous extracts. Int. J. Adv. Life Sci. 2013, 13, 60–70. [Google Scholar]
- Suh, I.K.; Ohta, H.; Waseda, Y. High-temperature thermal expansion of six metallic elements measured by dilatation method and X-ray Diffraction Locality: Synthetic Sample: At T = 576 K. J. Mater. Sci. 1988, 23, 757–760. [Google Scholar] [CrossRef]
- Mohammed, A.N.A.; Mohamed, A.; El-Naggar, N.A.; Mahrous, G.; Nasr, G.M.; Abdella, A.; Ahmed, B.H.; Irmak, S.; Elsayed, M.S.A.; Selim, S.; et al. Antioxidant and Antibacterial Activities of Silver Nanoparticles Biosynthesized by Moringa oleifera through Response Surface Methodology. J. Nanomater. 2022, 2022, 9984308. [Google Scholar] [CrossRef]
- Rasool, S.; Raza, M.A.; Manzoor, F.; Kanwal, Z.; Riaz, S.; Iqbal, M.J.; Naseem, S. Biosynthesis, characterization and anti-dengue vector activity of silver nanoparticles prepared from Azadirachta indica and Citrullus colocynthis. R. Soc. Open Sci. 2020, 7, 200540. [Google Scholar] [CrossRef]
- Moodley, J.S.; Krishna, S.B.; Pillay, K.; Govender, P. Green synthesis of silver nanoparticles from Moringa oleifera leaf extracts and its antimicrobial potential. Adv. Nat. Sci. Nanosci. Nanotechnol. 2018, 9, 015011. [Google Scholar] [CrossRef]
- Guimarães, M.L.; da Silva, F.A.G.M.; da Costa, M.; de Oliveira, H.P. Green synthesis of silver nanoparticles using Ziziphus joazeiro leaf extract for production of antibacterial agents. Appl. Nanosci. 2020, 10, 1073–1081. [Google Scholar] [CrossRef]
- Hamouda, R.A.; Hussein, M.H.; hbo-elmagd, R.A.; Bawazir, S.S. Synthesis and biological characterization of silver nanoparticles derived from the cyanobacterium Oscillatoria limnetica. Sci. Rep. 2019, 9, 13071. [Google Scholar] [CrossRef]
- Narayanan, V.A.; Jacob, R.; Paulson, J.M.; Dineshkumar, B.; Narayana, C.R. Mango leaf extract synthesized silver nanorods exert anticancer activity on breast cancer and colorectal carcinoma cells. J. Drug Deliv. Sci. Technol. 2018, 44, 8–12. [Google Scholar] [CrossRef]
- Banerjee, P.; Satapathy, M.; Mukhopahayay, A.; Papita Das, P. Leaf extract mediated green synthesis of silver nanoparticles from widely available Indian plants: Synthesis, characterization, antimicrobial property and toxicity analysis. Bioresour. Bioprocess. 2014, 1, 3. [Google Scholar] [CrossRef]
- Panwar, R.S.; Pervaiz, N.; Dhillon, G.; Kumar, S.; Sharma, N.; Aggarwal, N.; Tripathi, S.; Kumar, R.; Vashisht, A.; Kumar, N. Mangifera indica leaf extract assisted biogenic silver nanoparticles potentiates photocatalytic activity and cytotoxicity. J. Mater. Sci. Mater. Electron. 2022, 33, 16538–16549. [Google Scholar] [CrossRef]
- Botcha, S.; Prattipati, S.D. Callus extract mediated green synthesis of silver nanoparticles, their characterization and cytotoxicity evaluation against MDA-MB-231 and PC-3 Cells. BioNanoScience 2020, 10, 11–22. [Google Scholar] [CrossRef]
- Kumar, M.; Saurabh, V.; Tomar, M.; Hasan, M.; Changan, S.; Sasi, M.; Maheshwari, C.; Prajapati, U.; Singh, S.; Prajapat, R.K.; et al. Mango (Mangifera indica L.) Leaves: Nutritional Composition, Phytochemical Profile, and Health-Promoting Bioactivities. Antioxidants 2021, 10, 299. [Google Scholar] [CrossRef]
- Sahu, S.; Das, B.K.; Pradhan, J.; Mohapatra, B.C.; Mishra, B.K.; Sarangi, N. Effect of Mangifera indica kernel as a feed additive on immunity and resistance to Aeromonas hydrophila in Labeo rohita fingerlings. Fish Shellfish. Immunol. 2007, 23, 109–118. [Google Scholar] [CrossRef]
- Rather, M.A.; Bhat, I.A.; Sharma, N.; Gora, A.; Ganie, P.A.; Sharma, R. Synthesis and characterization of Azadirachta indica constructed silver nanoparticles and their immunomodulatory activity in fish. Aquac. Res. 2017, 48, 3742–3754. [Google Scholar] [CrossRef]
- Tahira, S.; Raja, J.I.; Iqbal, N.; Zia-ur-Rehman, M. Silver nanoparticles elicited physiological, biochemical, and antioxidant modifications in rice plants to control Aspergillus flavus. Green Process. Synth. 2021, 10, 314–324. [Google Scholar] [CrossRef]
- Blaxhall, P.C. The haematological assessment of the health of freshwater fsh, a review of selected literature. J. Fish Biol. 1972, 4, 593–604. [Google Scholar] [CrossRef]
- Nethi, S.K.; Das, S.; Patra, C.R.; Mukherjee, S. Recent advances in inorganic nanomaterials for wound-healing applications. Biomater. Sci. 2019, 7, 2652–2674. [Google Scholar] [CrossRef] [PubMed]
- Agarwal, H.; Nakara, A.; Shanmugam, V.K. Anti-inflammatory mechanism of various metal and metal oxide nanoparticles synthesized using plant extracts: A review. Biomed. Pharmacother. 2019, 109, 2561–2572. [Google Scholar] [CrossRef]
- Patil, S.; Chandrasekaran, R. Biogenic nanoparticles: A comprehensive perspective in synthesis, characterization, application and its challenges. J. Genet. Eng. Biotechnol. 2020, 18, 67. [Google Scholar] [CrossRef]
- Ong, C.K.S.; Lirk, P.; Tan, C.H.; Seymour, R.A. An evidence-based update on nonsteroidal anti-inflammatory drugs. Clin. Med. Res. 2007, 5, 19–34. [Google Scholar] [CrossRef] [PubMed]
- Kedi, P.B.E.; Meva, F.E.; Kotsedi, L.; Nguemfo, E.L.; Zangueu, C.B.; Ntoumba, A.A.; Mohamed, H.E.A.; Dongmo, A.B.; Maaza, M. Eco-friendly synthesis, characterization, in vitro and in vivo anti-inflammatory activity of silver nanoparticle-mediated Selaginella myosurus aqueous extract. Int. J. Nanomed. 2018, 13, 8537–8548. [Google Scholar] [CrossRef]
- Ahn, E.Y.; Jin, H.; Park, Y. Assessing the antioxidant, cytotoxic, apoptotic and wound healing properties of silver nanoparticles green-synthesized by plant extracts. Mater. Sci. Eng. C. 2019, 101, 204–216. [Google Scholar] [CrossRef] [PubMed]
- Donga, S.; Chanda, S. Facile green synthesis of silver nanoparticles using Mangifera indica seed aqueous extract and its antimicrobial, antioxidant and cytotoxic potential (3-in-1 system). Artif. Cells. Nanomed. Biotechnol. 2021, 49, 292–302. [Google Scholar] [CrossRef] [PubMed]
- Kandiah, M.; Chandrasekaran, K.N. Green Synthesis of Silver Nanoparticles Using Catharanthus roseus Flower Extracts and the Determination of Their Antioxidant, Antimicrobial, and Photocatalytic Activity. J. Nanotechnol. 2021, 2021, 5512786. [Google Scholar] [CrossRef]
- Zheng, W.; Wang, S.Y. Antioxidant Activity and Phenolic Compounds in Selected Herbs. J. Agric. Food Chem. 2001, 49, 5165–5170. [Google Scholar] [CrossRef] [PubMed]
- Patil Shriniwas, P.; Kumbhar Subhash, T. Antioxidant, antibacterial and cytotoxic potential of silver nanoparticles synthesized using terpenes rich extract of Lantana camara L. leaves. Biochem. Biophys. Rep. 2017, 10, 76–81. [Google Scholar] [CrossRef]
- Prasad, T.; Elumalai, E.K. Biofabrication of Ag nanoparticles using Moringa oleifera leaf extract and their antimicrobial activity. Asian Pac. J. Trop. Biomed. 2011, 1, 439–442. [Google Scholar] [CrossRef]
- Xing, Y.; Liao, X.; Liu, X.; Li, W.; Huang, R.; Tang, J.; Xu, Q.; Li, X.; Yu, J. Characterization and Antimicrobial Activity of Silver Nanoparticles Synthesized with the Peel Extract of Mango. Materials 2021, 14, 5878. [Google Scholar] [CrossRef]
- Balaz, M.; Bedlovicova, Z.; Daneu, N.; Siksa, P.; Sokoli, L.; Tkaacikovaa, L.; Salayovaa, A.; Dzunda, R.; Kovacova, M.; Bures, R.; et al. Mechanochemistry as an Alternative Method of Green Synthesis of Silver Nanoparticles with Antibacterial Activity: A Comparative Study. Nanomaterials 2021, 11, 1139. [Google Scholar] [CrossRef] [PubMed]
- Sharifi-Rad, M.; Pohl, P.; Epifano, F. Phytofabrication of Silver Nanoparticles (AgNPs) with Pharmaceutical Capabilities Using Otostegia persica (Burm.) Boiss. Leaf Extract. Nanomaterials 2021, 11, 1045. [Google Scholar] [CrossRef] [PubMed]
- Rafique, M.; Sadaf, I.; Tahira, M.B.; Rafique, M.S.; Nabi, G.; Iqbal, T.; Sughra, K. Novel and facile synthesis of silver nanoparticles using albizia procera leaf extract for dye degradation and antibacterial applications. Mater. Sci. Eng. C 2019, 99, 1313–1324. [Google Scholar] [CrossRef] [PubMed]
- Paul, B.; Bhuyan, B.; Purkayastha, D.D.; Dhar, S.S. Photocatalytic and antibacterial activities of gold and silver nanoparticles synthesized using biomass of Parkia roxburghii leaf. J. Photochem. Photobiol. B 2016, 154, 1–7. [Google Scholar] [CrossRef]
- Sondi, I.; Salopek-Sondi, B. Silver nanoparticles as antimicrobial agent: A case study on E. coli as a model for Gram-negative bacteria. J. Colloid. Interface. Sci. 2004, 275, 177–182. [Google Scholar] [CrossRef]

| G1 | G2 | G3 | G4 | G5 | G6 | G7 | |
|---|---|---|---|---|---|---|---|
| ALT (U/L | 44.5 ± 5.7 a | 102.5 ± 11.5 b | 105.6 ± 15.6 b | 78.1 ± 9.6 c | 66.9 ± 5.7 a | 95.7 ± 8.5 b | 50.1 ± 3.9 a |
| AST (U/L) | 17.3 ± 3.4 a | 25.6 ± 2.6 b | 24.3 ± 4.9 b | 22.7 ± 4.3 a | 23.1 ± 4.7 b | 27.9 ± 6.4 b | 15.6 ± 2.1 a |
| ALP (U/L) | 6.9 ± 1.1 a | 78.4 ± 4.6 b | 69.2 ± 7.8 b | 65.4 ± 10.5 b | 45.8 ± 5.1 b | 63.5 ± 8.2 b | 10.3 ± 4.4 a |
| TP (g/dL) | 3.9 ± 0.6 a | 7.8 ± 1.2 b | 6.5 ± 1.3 b | 7.1 ± 1.6 b | 5.8 ± 1.3 a | 6.2 ± 1.2 b | 3.2 ± 1.1 a |
| Alb (g/dL) | 1.9 ± 0.3 a | 4.5 ± 0.8 b | 3.1 ± 0.6 a | 3.5 ± 0.4 a | 3.1 ± 0.6 a | 2.9 ± 0.5 a | 1.4 ± 0.5 a |
| Glo (g/dL) | 2.0 ± 0.7 a | 3.3 ± 0.5 b | 3.4 ± 1.1 b | 3.6 ± 0.5 b | 2.7 ± 0.5 a | 3.3 ± 0.7 b | 1.8 ± 0.6 a |
| A/G | 0.95 ± 0.1 a | 1.3 ± 0.8 b | 0.91 ± 0.2 a | 0.97 ± 0.08 a | 1.14 ± 0.9 a | 0.87 ± 0.05 a | 1.02 ± 0.3 a |
| G1 | G2 | G3 | G4 | G5 | G6 | G7 | |
|---|---|---|---|---|---|---|---|
| TLC (×104/mm3) | 220 ± 12 a | 123 ± 21b | 150 ± 19 b | 199 ± 11 a | 185 ± 24 a | 143 ± 16 b | 193 ± 2 a |
| TEC (×106/mm3) | 156 ± 11 a | 78 ± 7 b | 98 ± 5 b | 123 ± 13 a | 132 ± 14 a | 9 3 ± 6 b | 137 ± 9 a |
| Hb (g/dl) | 9.3 ± 1.4 a | 6.7 ± 1.5 b | 7.1 ± 1.5 b | 7.8 ± 2.4 b | 8.7 ± 3.7 a | 7.1 ± 1.4 b | 9.1 ± 1.7 a |
| Hct (%) | 35 ±3 a | 12 ± 1 b | 22 ± 2 c | 32 ± 3 a | 39 ± 5 a | 25 ± 6 c | 42 ± 5 a |
| Lym | 198 ± 21 a | 73 ± 3 b | 99 ± 12 b | 123 ± 8 b | 187 ± 27 a | 112 ± 16 b | 188 ± 16 a |
| Mon | 86 ± 8 a | 34 ± 3 b | 71 ± 9 a | 85 ± 3 a | 91 ± 7 a | 56 ± 13 b | 75 ± 7 a |
| Bas | 45 ± 3 a | 12 ± 2 b | 25 ± 4 c | 34 ± 3 c | 47 ± 4 a | 36 ± 8 c | 50 ± 5 a |
| Eos | 14 ± 2 a | 10 ± 1 b | 12 ± 1 b | 16 ± 2 a | 15 ± 3 a | 13.5 ± 2 a | 17 ± 4 a |
| Neu | 77 ± 6 a | 48 ± 3 b | 60 ± 5 b | 72 ± 13 a | 71 ± 7 a | 58 ± 5 b | 65 ± 7 a |
| G1 | G2 | G3 | G4 | G5 | G6 | G7 | |
|---|---|---|---|---|---|---|---|
| MDA (mol/mg) (Gills) | 14.2 ± 2.5 a | 43.1 ± 4.2 b | 39.9 ± 7.3 b | 22.33 ± 0.5 a | 19.5 ± 2.6 a | 40.7 ± 3.7 b | 18.5 ± 1.7 a |
| MDA (mol/mg) (Liver) | 8.3 ± 0.7 a | 34.5 ± 1.4 b | 23.6 ± 1.1 c | 18.5 ± 0.5 c | 12.5 ± 0.8 a | 30.3 ± 1.4 b | 7.8 ± 0.6 a |
| SOD (U/mg) (Gills) | 178.2 ± 11.7 a | 90.9 ± 7.9 b | 87.6 ± 7.6 b | 114 ± 12.5 b | 162 ± 7.5 a | 72.6 ± 4.7 b | 165.4 ± 13.1 a |
| SOD (U/mg) (Liver) | 222.4 ± 15.2 a | 162.1 ± 1 7.3 b | 187.8 ± 10.6 b | 200.9 ± 14.8 a | 212 ± 12.5 a | 186.3 ± 6.7 b | 196.3 ± 23.5 a |
| CAT (U/mg) (Gills) | 56.4 ± 3.6 a | 21.5 ± 2.9 b | 35.7 ± 5.7 b | 45.6 ± 4.7 a | 49.7 ± 6.3 a | 31.5 ± 2.6 b | 62.1 ± 4.9 a |
| CAT (U/mg) (Liver) | 68.7 ± 6.4 a | 35.4 ± 4.8 b | 55.2 ± 8.8 a | 63.9 ± 7.4 a | 57.4 ± 3.6 a | 48.1 ± 5.8 b | 61.7 ± 5.7 a |
| GPx (U/mg) (Gills) | 35 ± 3.5 a | 12 ± 1.6 b | 22 ± 2.4 c | 32 ± 3.8 a | 45 ± 5.3 a | 25 ± 6.7 c | 32.5 ± 4.1a |
| GPx (U/mg) (Liver) | 47.7 ± 5.1 a | 23.5 ± 2.8 b | 28.7 ± 1.2 b | 37.2 ± 3 c | 41.6 ± 3.6 a | 33.5 ± 2.5 b | 53.4 ± 6.2 a |
Disclaimer/Publisher’s Note: The statements, opinions and data contained in all publications are solely those of the individual author(s) and contributor(s) and not of MDPI and/or the editor(s). MDPI and/or the editor(s) disclaim responsibility for any injury to people or property resulting from any ideas, methods, instructions or products referred to in the content. |
© 2023 by the authors. Licensee MDPI, Basel, Switzerland. This article is an open access article distributed under the terms and conditions of the Creative Commons Attribution (CC BY) license (https://creativecommons.org/licenses/by/4.0/).
Share and Cite
Raza, M.A.; Kanwal, Z.; Riaz, S.; Amjad, M.; Rasool, S.; Naseem, S.; Abbas, N.; Ahmad, N.; Alomar, S.Y. In-Vivo Bactericidal Potential of Mangifera indica Mediated Silver Nanoparticles against Aeromonas hydrophila in Cirrhinus mrigala. Biomedicines 2023, 11, 2272. https://doi.org/10.3390/biomedicines11082272
Raza MA, Kanwal Z, Riaz S, Amjad M, Rasool S, Naseem S, Abbas N, Ahmad N, Alomar SY. In-Vivo Bactericidal Potential of Mangifera indica Mediated Silver Nanoparticles against Aeromonas hydrophila in Cirrhinus mrigala. Biomedicines. 2023; 11(8):2272. https://doi.org/10.3390/biomedicines11082272
Chicago/Turabian StyleRaza, Muhammad Akram, Zakia Kanwal, Saira Riaz, Maira Amjad, Shafqat Rasool, Shahzad Naseem, Nadeem Abbas, Naushad Ahmad, and Suliman Yousef Alomar. 2023. "In-Vivo Bactericidal Potential of Mangifera indica Mediated Silver Nanoparticles against Aeromonas hydrophila in Cirrhinus mrigala" Biomedicines 11, no. 8: 2272. https://doi.org/10.3390/biomedicines11082272
APA StyleRaza, M. A., Kanwal, Z., Riaz, S., Amjad, M., Rasool, S., Naseem, S., Abbas, N., Ahmad, N., & Alomar, S. Y. (2023). In-Vivo Bactericidal Potential of Mangifera indica Mediated Silver Nanoparticles against Aeromonas hydrophila in Cirrhinus mrigala. Biomedicines, 11(8), 2272. https://doi.org/10.3390/biomedicines11082272

